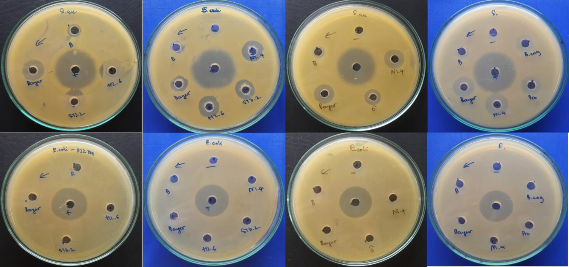
Hình 4 5 Khả năng kháng các chủng vi khuẩn kiểm định của các chủng phân 2

Hình 4.4. Cây phát sinh chủng loại của chủng vi khuẩn chọn lọc N1.4 với các trình tự gen trên GenBank có mức độ tương đồng cao nhất
Căn cứ vào cây phân loại và bảng so sánh mức độ tương đồng về trình tự nucleotide của chủng vi sinh vật N1.4 và trình tự gen của 13 chủng vi khuẩn Bacillus (trên Genbank) đã được biết trình tự có thể rút ra một số nhận xét như sau:
- Chủng N1.4 có chung nguồn gốc phát sinh với 13 chủng vi khuẩn Bacillus có trình tự xác định trên Genbank, do đó có thể khẳng định chủng N1.4 là một chủng vi khuẩn thuộc chi Bacillus.
- Trong 13 chủng Bacillus này, có 2 chủng: Bacillus sp. JN14, Bacillus sp. CZB20 là chưa được xác định rò thuộc loài nào, tuy nhiên căn cứ vào mức độ tương đồng về nucleotide và cây phân loại có thể dự đoán N1.4 thuộc loài Bacillus subtilis.
- Chủng N1.4 có hệ số tương đồng rất cao với 13 chủng so sánh, hệ số này là 99.85%. Trên hình vẽ cây phân loại chỉ ra rằng, N1.4 có mối quan hệ gần gũi nhất về mặt di truyền với chủng B.subtilis LFB112 (tỷ lệ tương đồng 99.85%).
Từ các chủng phân lập được, kết quả định danh chủng vi khuẩn N1.4 thuộc loài Bacillus subtilis dựa trên trình tự rADN 16S. Chủng vi khuẩn tiềm năng B. subtilis N1.4 này có khả năng sinh bacteriocin ức chế mạnh vi khuẩn kiểm định (S.aureus, V.harveyi, V. parahaemolyticus) và sinh enzyme (amylase, cellulase, protease) thủy phân cơ chất tương ứng như chất bột, cellulose và protein.
4.3. Nghiên cứu xác định thành phần môi trường dinh dưỡng và điều kiện lên men phù hợp cho quá trình sinh tổng hợp bacteriocin
4.3.1. Ảnh hưởng của hoạt tính kháng khuẩn qua các thế hệ nuôi cấy
Khả năng kháng các chủng vi khuẩn kiểm định của các chủng phân lập được qua các thế hệ từ 2 đến 5 trên môi trường LB, 37°C sau 24 giờ được trình bày trên hình 4.5.
Hình 4.5. Khả năng kháng các chủng vi khuẩn kiểm định của các chủng phân lập được qua các thế hệ từ 2 đến 5
Kết quả đạt được cho thấy, chủng chọn lọc B.subtilis N1.4 thể hiện hoạt tính ổn định về khả năng sinh enzyme (amylase, celllase, protease) và khả năng ức chế các vi khuẩn kiểm định S.aureus, V.harveyi, V. parahaemolyticus) qua 5 thế hệ.
4.3.2. Nghiên cứu đặc điểm nuôi cấy của chủng Bacillus subtilis N1.4
4.3.2.1. Nghiên cứu lựa chọn môi trường nuôi cấy
Thực hiện các thí nghiệm theo mô tả trong mục 3.3.3, kết quả các nghiên cứu xác định thành phần môi trường dinh dưỡng của chủng Bacillus subtilis N1.4 được trình bày trên bảng 4.4:
Bảng 4.4. Ảnh hưởng của môi trường nuôi cấy đến chủng Bacillus subtilis N1.4
Max OD | Max AU/ml | |
LB lỏng cơ bản | 2,9 | 40 |
NB lỏng cơ bản | 3,2 | 60 |
LB được chọn lọc bổ sung với: | ||
CuSO4, NaHCO3,NaNO3, MnSO4, KCl, CaCl2, MgCl2, ZnSO4 | 4,3 | 140 |
CuSO4, NaHCO3, NaNO3, MnSO4 | 0,6 | 80 |
KCl, CaCl2, MgCl2, ZnSO4 | 3,2 | 140 |
KCl, MgCl2 | 2,3 | 280 |
CaCl2, ZnSO4 | 2,7 | 300 |
CuSO4, NaNO3 | 2,4 | 80 |
MnSO4, NaHCO3 | 2,5 | 290 |
KCl | 2,8 | 140 |
MgCl2 | 3,7 | 140 |
CaCl2 | 2,9 | 80 |
ZnSO4 | 2,4 | 80 |
NaNO3 | 2,8 | 40 |
MnSO4 | 5,4 | 140 |
CuSO4 | 2,8 | 40 |
NaHCO3 | 2,5 | 80 |
Có thể bạn quan tâm!
-
Đối Tượng, Nội Dung Và Phương Pháp Nghiên Cứu -
Định Danh Chủng Vi Sinh Vật Có Khả Năng Sinh Tổng Hợp Bacteriocin Đã Được Tuyển Chọn -
Khả Năng Sinh Tổng Hợp Enzyme Amylase, Cellulase Và Protease -
Phân lập và tuyển chọn chủng probiotic sinh tổng hợp bacteriocin từ ruột tôm nước mặn tỉnh Nam Định để ứng dụng trong sản xuất thức ăn chăn nuôi tôm - 8 -
Phân lập và tuyển chọn chủng probiotic sinh tổng hợp bacteriocin từ ruột tôm nước mặn tỉnh Nam Định để ứng dụng trong sản xuất thức ăn chăn nuôi tôm - 9
Xem toàn bộ 81 trang tài liệu này.
Môi trường nuôi cấy được pha chế gồm môi trường LB có bổ sung các chất dinh dưỡng theo các phương án khác nhau. Môi trường LB có bổ sung các chất
phụ gia (CaCl2, ZnSO4) cho hoạt tính bacteriocin cao nhất (300 AU /ml) và mật độ quang học (OD) đạt 2,7 trong quá trình sinh trưởng của chủng N1.4.
Môi trường LB có bổ sung khoáng chất CaCl2, ZnSO4 này này được sử dụng cho các nghiên cứu tiếp theo.
4.3.2.2. Nghiên cứu điều kiện lên men cho quá trình sinh tổng hợp bacteriocin của chủng Bacillus subtilis N1.4
Thực hiện các thí nghiệm theo mô tả trong mục 3.3.3, ảnh hưởng của các yếu tố nghiên cứu đến khả năng sinh kháng khuẩn bacteriocin của chủng N1.4 được trình bày trong bảng 4.5.
Bảng 4.5. Ảnh hưởng của điều kiện lên men cho quá trình sinh tổng hợp bacteriocin
Yếu tố nghiên cứu | AU ở mỗi giá trị nghiên cứu của các yếu tố ảnh hưởng | ||||||||
1 | Tốc độ khuấy vòng/phút | 140 | 150 | 160 | 170 | 180 | 200 | 220 | |
AU/ml | 80 | 140 | 200 | 280 | 300 | 280 | 240 | ||
2 | pH môi trường | 4 | 5 | 6 | 7 | 8 | 9 | 10 | |
AU/ml | 60 | 150 | 265 | 312 | 240 | 160 | 130 | ||
3 | Nhiệt độ (oC) lên men | 31 | 33 | 35 | 37 | 39 | 41 | 43 | 45 |
AU/ml | 120 | 180 | 280 | 345 | 270 | 220 | 140 | 100 | |
4 | Mật độ giống (cfu/ml) | 106 | 107 | 108 | |||||
AU/ml | 140 | 351 | 250 | ||||||
5 | Thời gian lên men (giờ) | 24 | 48 | 72 | 96 | ||||
AU/ml | 220 | 381 | 280 | 240 |
* Thí nghiệm sau sẽ sử dụng giá trị tối ưu của thí nghiệm nghiên cứu trước đó nếu như không giải thích gì thêm.
Bảng 4.5 cho thấy, chủng B.subtilis N1.4 lên men trong môi trường được chọn lọc kết hợp với các điều kiện lên men cho những kết quả như sau:
- Tốc độ khuấy 180 vòng/phút cho hoạt tính AU cao nhất
- Ở pH 7,0 cho hoạt tính cao nhất;
- Ở nhiệt độ 37oC cho hoạt tính cao nhất;
- Ở mật độ giống ban đầu 107 cfu/ml cho hoạt tính cao nhất;
- Sau 48 giờ lên men cho hoạt tính cao nhất.
Như vậy, kết quả nghiên cứu các điều kiện lên men cho thấy cho thấy, khi kết hợp các yếu tố tối ưu như môi trường tối ưu LB g/l ( pepton 10, cao thịt bò 10, NaCl 5) và có bổ sung CaCl2, ZnSO4 mỗi loại 1 mM, pH 7,0, nuôi lắc 180 vòng/phút, ở 37oC, 48 giờ lên men, giống 107 cfu/ml cho hoạt tính cao 381 AU/ml.
4.3.2.3. Ảnh hưởng của thời gian lên men đến hoạt tính kháng khuẩn
Thời gian lên men có ảnh hưởng quan trọng đến hoạt tính kháng khuẩn của chủng N1.4 đối với các chủng kiểm định (bảng 4.6).
Bảng 4.6. Ảnh hưởng của thời gian lên men đến khả năng kháng khuẩn
Đường kính vòng ức chế (mm) | |||||
Thời gian (giờ) | E.coli | Salmonella | S.aureus | V.harveyi | V.paraheamolyticus |
24 | - | 2 | 8 | - | 2 |
48 | - | 13 | 15 | - | 14 |
72 | - | 2 | 7 | - | 3 |
96 | - | + | 7 | - | 2 |
120 | - | + | 5 | - | + |
Từ kết quả đạt được cho thấy, chủng N1.4 không có khả năng kháng E.coli và V.harveyi, trong khi đó, hoạt tính kháng Salmonella và V.paraheamolyticus giảm dần sau 48 giờ lên men. Hoạt tính kháng S.aureus đạt giá trị cao nhất sau 48 giờ (15mm) và giảm dần sau đó.
Sau 48 giờ lên men, hoạt tính kháng khuẩn đạt cao nhất, tại các thời gian lên men khác hoạt tính kháng khuẩn có giá trị thấp hơn. Thời gian 48 giờ lên men được lựa chọn cho các nghiên cứu tiếp theo.
4.1.1.1. Ảnh hưởng của thời gian lên men đến hoạt tính enzyme thuỷ phân
Thời gian lên men có ảnh hưởng đến hoạt tính của enzyme thuỷ phân, sinh tổng hợp được từ chủng N1.4 (bảng 4.7).
Bảng 4.7. Ảnh hưởng của thời gian lên men đến hoạt tính enzyme thủy phân
Đường kính vòng phân giải cơ chất (mm) | |||
Amylase | Cellulase | Protease | |
24 | + | 10 | 11 |
48 | 31 | 30 | 24 |
72 | 21 | 19 | 17 |
96 | + | 8 | 11 |
120 | + | 9 | 14 |
Sau 48 giờ lên men hoạt tính enzyme thuỷ phân thu được đạt cao nhất. Hoạt tính enzyme cellulase và protease qua các ngày lên men cũng có sự khác nhau nhưng không nhiều.
Thời gian 48 giờ được lựa chọn để lên men sinh enzyme cho chủng N1.4.
4.4. Nghiên cứu xây dựng phương pháp thu nhận sản phẩm bacteriocin quy mô phòng thí nghiệm
4.4.1. Nghiên cứu quy trình thu nhận bacteriocin
Dịch sau lên men, dịch nổi được thu bằng li tâm ở 10000 vòng/phút. Li tâm trong 10 phút. Dịch nổi được xử lý với các dung môi khác nhau như etyl axetat đã chọn, n-butanol, n-hexan, diclometan để tìm dung môi phù hợp. Dịch chiết được cô đặc bằng cô quay sau đó hoàn nguyên bằng đệm photphat.
Bảng 4.8. Khả năng chiết tách của các dung môi khác nhau đối với bateriocins từ dịch nổi
Salmonella, | S.aureus | |
ethyl axetat | +++ | ++++ |
n-butanol, | - | - |
n-hexan, | - | - |
diclometan | - | - |
Trong các dung môi được sử dụng trong nghiên cứu để tách bacteriocin, ethyl axetat cho khả năng tách bacteriocin tốt nhất, dung môi này cho khả năng tách hoạt chất kháng khuẩn Salmonella và S.aureus cao. Do đó dung môi này được sử dụng cho các nghiên cứu tiếp theo.
Chủng giống N1.4
Lên men 500 mL, li tâm thu dịch
Lọc qua màng Minipore
Tủa với muối sulfat amôn
Thử hoạt tính
Chiết với dung môi ethyl acetate
Thử hoạt tính
Cô đặc phân đoạn, hoàn nguyên trong PSB
Bacteriocin thô/thử hoạt tính
Hình 4.6. Qui trình chiết tách bacteriocin từ chủng N1.4
Từ các kết quả nghiên cứu trên, chúng tôi đưa ra phương pháp chiết tách bacteriocin gồm 7 bước như sau:
Bước 1: Chủng chọn lọc được lấy từ tủ âm -70oC, hóa lỏng trong điều kiện phòng, cấy chủng trên đĩa LB thạch, ở 37oC, trong 2 ngày.
Bước 2: Lấy 1 lượng sinh khối chủng vi khuẩn cấy vào môi trường lỏng LB tối ưu (500 ml), nuôi lắc 180 vòng/phút, 2 ngày, ở 37oC.
Bước 4: Dịch lên men ly tâm ở 10,000 vòng/phút/10 phút. Sinh khối tế bào được trộn với tinh bột tan (1/2, 1 phần sinh khối, 2 phần tinh bột tan) và làm khô





